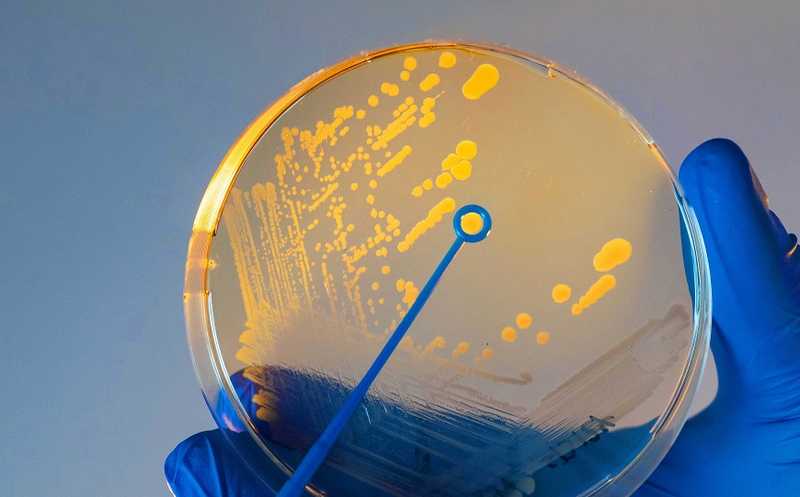

Холерный вибрион против бактериофага: битва малых РНК
Бактериофаги могут «подслушивать» химические сигналы, которые обеспечивают чувство кворума у бактерий, и активировать собственное размножение, когда вокруг много хозяйских клеток. Исследователи из Йенского университета установили, что важную роль в этом играют малые РНК. Они нашли РНК бактериофага VP882, заражающего холерный вибрион, которая активирует размножение фага и лизис бактериальной клетки. Также обнаружены бактериальные малые РНК, которые подавляют этот процесс.
Вирусы поражают не только животных и растений, но и микроорганизмы; вирусы бактерий называются бактериофагами или просто фагами. Возможно, бактериофаги — самые распространенные биообъекты в окружающей среде. Бактерии, в свою очередь, приобретают механизмы защиты; атаки фагов — один из основных движущих факторов их эволюции. Среди этих защитных систем наиболее известны CRISPR-Cas, но есть и другие. Однако и фаги разрабатывают сложные пути противодействия защитным системам, таким образом, продолжается гонка вооружений между фагами и их хозяевами. Ученые из Йенского университета (Германия) исследовал сложное взаимодействие этих стратегий атаки и защиты на примере холерного вибриона (Vibrio cholerae) и его бактериофага VP882. Было обнаружено, что решающую роль в этом играют малые РНК, кодируемые как фагом, так и бактерией.
Существует два варианта жизненного цикла бактериофага в клетке хозяина — литический и лизогенный. Литический путь приводит к разрыву и гибели клетки и высвобождению новых вирусных частиц. При лизогенном пути вирус не наносит клетке немедленных повреждений, и фаговый геном при каждом делении копируется вместе с геномом хозяина. Какую стратегию выберет фаг, зависит, в частности, от того, есть ли рядом с зараженной клеткой другие клетки потенциальных хозяев. Оказывается, фаги умеют это определять.
Многие, если не все бактерии для контроля коллективного поведения используют метод, известный как «чувство кворума» (quorum sensing, QS): выделяют в окружающую среду сигнальные молекулы и следят за концентрацией этих молекул с помощью специфических рецепторов, тем самым получая информацию о численности своей популяции.
Вирусы и фаги долгое время считались «одиночными» существами. Однако в настоящее время известно, что у фагов существуют их собственные коммуникационные системы, подобные бактериальному чувству кворума. Фаги научились производить собственные коммуникационные молекулы или «подслушивать» коммуникационные процессы хозяина, тем самым выбирая между литическим и лизогенным способами размножения.
Например, фаг phi3T, инфицирующий Bacillus subtilis, способен определять концентрацию фагов в окружающей среде, реагируя на специальные пептиды, которые кодируются его собственными генами, и «использовать» эту информацию для выбора между литическим и лизогенным образом жизни. А фаг холерного вибриона VP882 кодирует транскрипционный фактор, гомологичный белку хозяина VqmA, который отвечает за чувство кворума. И белок фага, и белок бактерии реагируют на молекулу 3,5-диметилпиразин-2-ола (ДПО), сигнализирующую о повышенной плотности клеток, при этом фаговый белок VqmA активирует литический путь. Подобные системы коммуникации обнаружены в геномах сотен фагов.
Работа исследователей из Йенского университета принесла новую информацию о взаимодействии холерного вибриона и фага VP882, который переключается с лизогенного пути на литический с помощью молекулы ДПО.
Связывание ДПО с бактериальным VqmA активирует синтез малой РНК VqmR — регулятора генов вирулентности. Эта малая РНК, в свою очередь, взаимодействует с бактериальным РНК-шапероном Hfq — это один из ключевых белков, которые обеспечивают правильную укладку, стабильность и устойчивость РНК в клетке, а также облегчает взаимодействия между двумя РНК.
Чтобы выяснить, что изменяется при фаговой инфекции, исследователи получили транскриптомы холерного вибриона и фага в нескольких временных точках после активации программы лизиса с помощью ДПО. Изменения затронули сотни РНК-транскриптов, но в том числе авторы установили, что фаговые РНК связываются с Hfq и это снижает активность бактериальных Hfq-связывающих мРНК. Основным партнером Hfq оказалась фаговая малая РНК VpdS, которая кодируется 3'-нетранслируемой областью (UTR) гена gp29 и является продуктом процессинга РНКазой E.
Чтобы выявить взаимодействия между молекулами РНК в культурах бактерий, авторы использовали метод RIL-seq (RNA interaction by ligation and sequencing): сшивание двух РНК, взаимодействующих с Hfq, получение общей для них кДНК и ее секвенирование. Выяснилось, что после активации фага шаперон Hfq опосредует образование множества дуплексов между молекулами РНК фага и хозяина; VpdS взаимодействует с различными транскриптами хозяина и фага и, по-видимому, контролирует экспрессию бактериальных генов, связывая молекулы мРНК вибриона. Таким образом среди прочих регулируются гены, которые могут способствовать противофаговой активности.
 Credit:
Пресс-релиз
Credit:
Пресс-релиз
Роль VpdS подтвердили, заражая бактерии фагами дикого типа и мутантными фагами. Мутация в гене vpdS задерживала репликацию фага и лизис клеток. А сверхэкспрессия VpdS с гена на плазмиде, напротив, замедляла рост клеток и ускоряла лизис при активации фага. Авторы также обнаружили хозяйскую малую РНК TarB, которая ингибирует экспрессию генов лизиса и мешает репликации фага. Существуют и другие малые РНК хозяина, способные участвовать в защите — путем прямой регуляции фаговых генов либо модуляции экспрессии генов стресса.
Таким образом, при появлении в среде ДПО (то есть тогда, когда бактериальных клеток много) малая фаговая РНК VpdS контролирует переключение VP882 на литический путь, ведущий к смерти клетки-хозяина. Кроме того, авторы выявили бактериальные малые РНК, противодействующие размножению вируса. По словам руководителя работы Кая Папенфорта, бактериальные противофаговые РНК особенно интересны: «Мы можем рассматривать их как предшественников иммунной системы высших организмов. У бактерий есть много генов, которые защищают их от вирусов». Исследователи предполагают, что аналогичные РНК могут быть и у эукариотических организмов.
Пациента с муковисцидозом вылечили от микобактериальной инфекции с помощью бактериофагов
Источники
Sprenger M., et al.: Small RNAs direct attack and defence mechanisms in a quorum sensing phage and its host // Cell. Host & Microbe (2024). DOI: 10.1016/j.chom.2024.03.010
Цитата по пресс-релизу


 Меню
Меню





 Все темы
Все темы




 0
0












